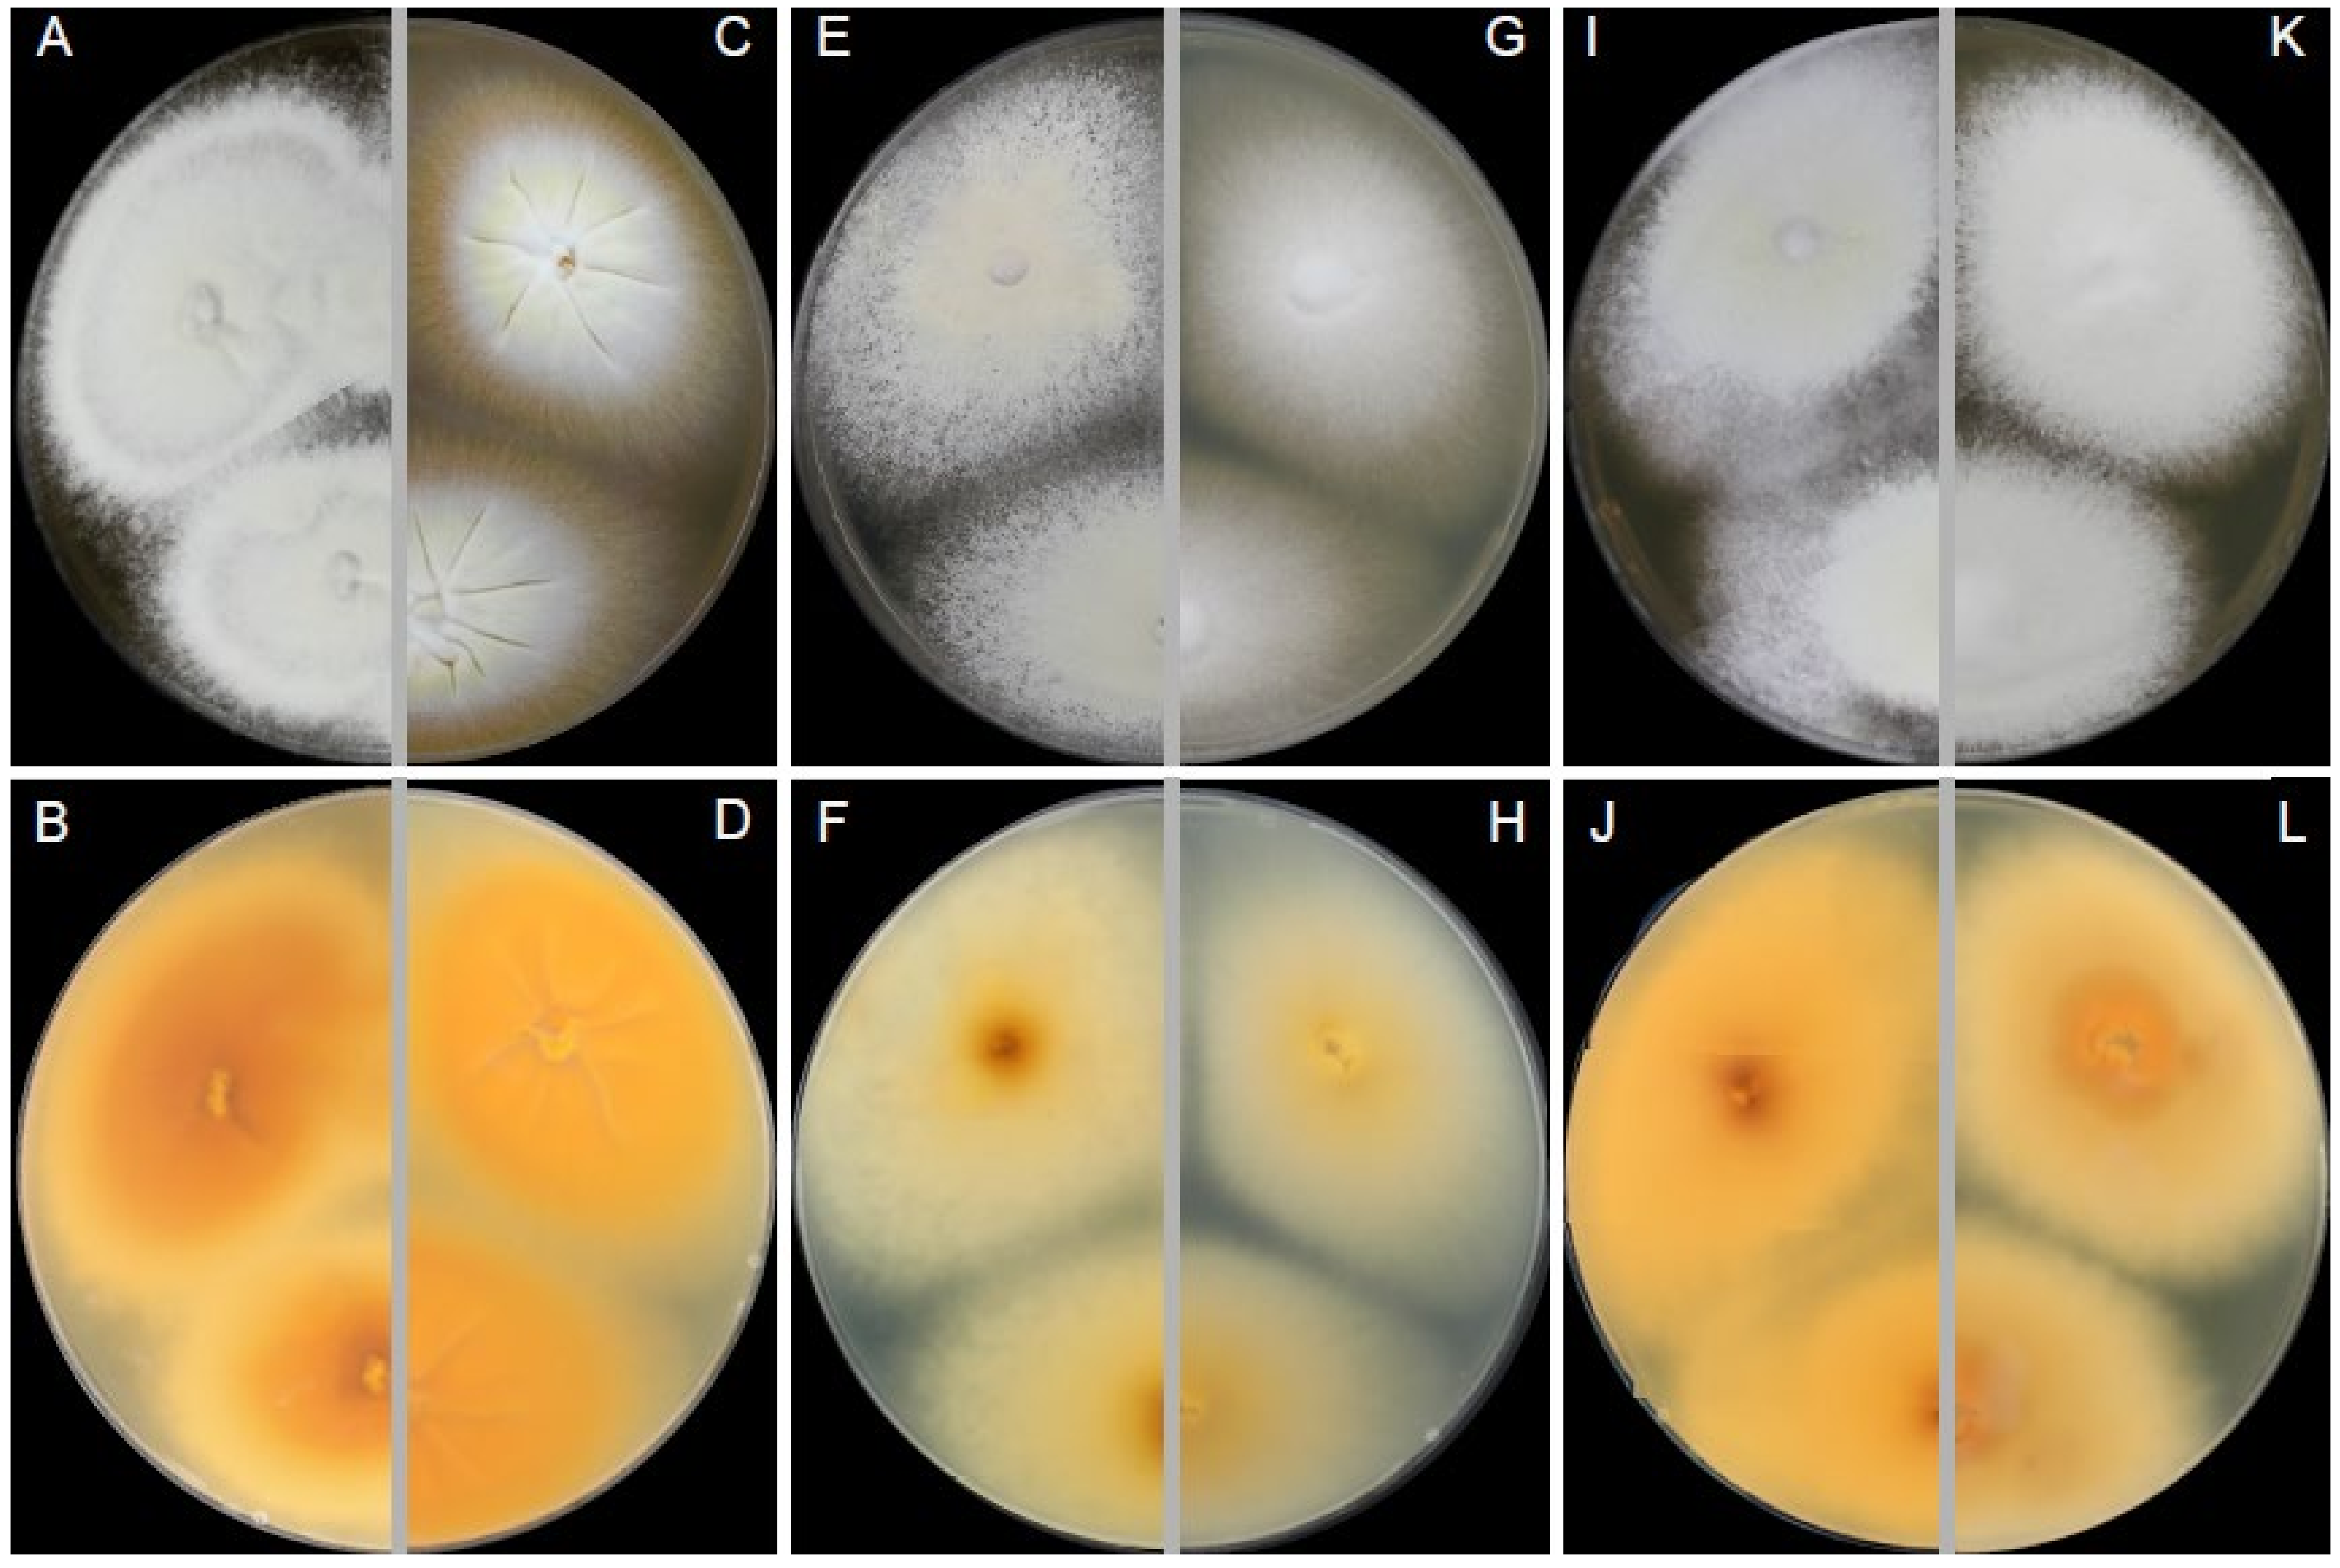
Jof 07 00074 g005 Jof 07 00074 g005

Detection and Control of Dermatophytosis in Wild European Hedgehogs (Erinaceus europaeus) Admitted to a French Wildlife Rehabilitation Centre
Abstract
1. Introduction
2. Materials and Methods
2.1. Bioethics
2.2. Animals and Sampling
2.3. Treatment Protocols
2.4. Culture and Dermatophyte Identification
2.5. Statistical Analysis
3. Results
3.1. Dermatophyte Detection and Identification
3.2. Morphological Characterisation of Dermatophytes
3.3. Epidemiological and Therapeutic Analysis
4. Discussion
Supplementary Materials
Author Contributions
Funding
Institutional Review Board Statement
Informed Consent Statement
Data Availability Statement
Acknowledgments
Conflicts of Interest
References
- Čmoková, A.; Kolařík, M.; Dobiáš, R.; Hoyer, L.L.; Janouškovcová, H.; Kano, R.; Kuklová, I.; Lysková, P.; Machová, L.; Maier, T.; et al. Resolving the Taxonomy of Emerging Zoonotic Pathogens in the Trichophyton benhamiae Complex. Fungal Divers. 2020, 104, 333–387. [Google Scholar] [CrossRef]
- Quaife, R.A. Human Infection Due to the Hedgehog Fungus, Trichophyton mentagrophytes var. erinacei. J. Clin. Pathol. 1966, 19, 177–178. [Google Scholar] [CrossRef] [PubMed]
- Bourdin, M. Relations Épidémiologiques Entre Dermatophyties Animales et Humaines. Méd. Mal. Infect. 1973, 3, 539–547. [Google Scholar] [CrossRef]
- English, M.P.; Evans, C.D.; Hewitt, M.; Warin, R.P. Hedgehog Ringworm. Br. Med. J. 1962, 1, 149–151. [Google Scholar] [CrossRef] [PubMed]
- Sidwell, R.U.; Chan, I.; Francis, N.; Bunker, C.B. Trichophyton erinacei Kerion Barbae from a Hedgehog with Direct Osculatory Transfer to Another Person. Clin. Exp. Dermatol. 2014, 39, 38–40. [Google Scholar] [CrossRef]
- Kim, J.; Tsuchihashi, H.; Hiruma, M.; Kano, R.; Ikeda, S. Tinea Corporis Due to Trichophyton erinacei Probably Transmit- Ted from a Hedgehog: The Second Case Report from Japan. Med. Mycol. J. 2018, 59, 77–79. [Google Scholar] [CrossRef]
- Ingham, M.J. Wildlife Nursing and Rehabilitation. Vet. Nurs. J. 1991, 6, 11–14. [Google Scholar] [CrossRef]
- Mitchell-Jones, A.J.; Amori, G.; Bogdanowicz, W.; Kryštufek, B.; Reijnders, P.J.H.; Spitzenberger, F.; Stubbe, M.; Thissen, J.B.M.; Vohralík, V.; Zima, J. The Atlas of European Mammals; Academic Press: London, UK, 1999. [Google Scholar]
- Williams, B.; Mann, N.; Neumann, J.L.; Yarnell, R.W.; Baker, P.J. A Prickly Problem: Developing a Volunteer-Friendly Tool for Monitoring Populations of a Terrestrial Urban Mammal, the West European Hedgehog (Erinaceus europaeus). Urban Ecosyst. 2018, 21, 1075–1086. [Google Scholar] [CrossRef]
- Wilson, E.; Wembridge, D. The State of Britain’s Hedgehogs 2018; British Hedgehog Preservation Society: London, UK; People’s Trust for Endangered Species: London, UK, 2018; 4p. [Google Scholar]
- Arrêté Du 17 Avril 1981 Fixant La Liste Des Mammifères Protégés Sur l’ensemble Du Territoire—Légifrance. Available online: https://www.legifrance.gouv.fr/loda/id/LEGITEXT000006074394/2007-05-10/ (accessed on 1 July 2020).
- Morris, P.; English, M.P. Trichophyton mentagrophytes var. erinacei in British Hedgehogs. Sabouraudia J. Med. Vet. Mycol. 1969, 7, 122–128. [Google Scholar] [CrossRef]
- Contet-Audonneau, N.; Saboureau, M.; Percebois, G. Trichophyton erinacei Chez Le Hérisson. J. Mycol. Méd. 1991, 1, 29–32. [Google Scholar]
- Hof, A.; Bright, P. The Value of Green-Spaces in Built-up Areas for Western Hedgehogs. Lutra 2009, 52, 69–82. [Google Scholar]
- Hubert, P.; Julliard, R.; Biagianti, S.; Poulle, M.-L. Ecological Factors Driving the Higher Hedgehog (Erinaceus europeaus) Density in an Urban Area Compared to the Adjacent Rural Area. Landsc. Urban Plan. 2011, 103, 34–43. [Google Scholar] [CrossRef]
- Wright, P.G.R.; Coomber, F.G.; Bellamy, C.C.; Perkins, S.E.; Mathews, F. Predicting Hedgehog Mortality Risks on British Roads Using Habitat Suitability Modelling. PeerJ. 2020, 7, e8154. [Google Scholar] [CrossRef] [PubMed]
- Riley, P.Y.; Chomel, B.B. Hedgehog Zoonoses. Emerg. Infect. Dis. 2005, 11, 1–5. [Google Scholar] [CrossRef]
- Bexton, S.; Nelson, H. Comparison of Two Systemic Antifungal Agents, Itraconazole and Terbinafine, for the Treatment of Dermatophytosis in European Hedgehogs (Erinaceus europaeus). Vet. Dermatol. 2016, 27. [Google Scholar] [CrossRef]
- Mariat, F.; Adan-Campos, C. La Technique Du Carré de Tapis, Méthode Simple de Prélèvement Dans Les Mycoses Superficielles. Ann. Inst. Pasteur 1967, 113, 666–668. [Google Scholar]
- de Hoog, G.; Guarro, J.; Gené, J.; Ahmed, S.; Al-Hatmi, A.; Figueras, M.; Vitale, R. Atlas of Clinical Fungi, 2nd ed.; Centraalbureau voor Schimmelcultures: Utrecht, The Netherlands; Reus, Spain, 2000. [Google Scholar]
- Atlas, R.M. Handbook of Microbiological Media; CRC Press: Boca Raton, FL, USA, 2010; ISBN 978-0-429-13049-6. [Google Scholar]
- Kelly, K.L.; Judd, D.B.; Inter-Society Color Council; United States National Bureau of Standards. ISCC-NBS Color-Name Charts Illustrated with Centroid Colors: Supplement to NBS Circular 553; Inter-Society Color Council: Frederick, MD , USA; U.S. Department of Commerce, National Bureau of Standards: Washinton, DC, USA, 1964. [Google Scholar]
- Hubka, V.; Nováková, A.; Jurjević, Ž.; Sklenář, F.; Frisvad, J.C.; Houbraken, J.; Arendrup, M.C.; Jørgensen, K.M.; Siqueira, J.P.Z.; Gené, J.; et al. Polyphasic Data Support the Splitting of Aspergillus candidus into Two Species; Proposal of Aspergillus dobrogensis sp. nov. Int. J. Syst. Evol. Microbiol. 2018, 68, 995–1011. [Google Scholar] [CrossRef]
- Gardes, M.; Bruns, T.D. ITS Primers with Enhanced Specificity for Basidiomycetes—Application to the Identification of Mycorrhizae and Rusts. Mol. Ecol. 1993, 2, 113–118. [Google Scholar] [CrossRef]
- Réblová, M.; Hubka, V.; Thureborn, O.; Lundberg, J.; Sallstedt, T.; Wedin, M.; Ivarsson, M. From the Tunnels into the Treetops: New Lineages of Black Yeasts from Biofilm in the Stockholm Metro System and Their Relatives among Ant-Associated Fungi in the Chaetothyriales. PLoS ONE 2016, 11, e0163396. [Google Scholar] [CrossRef]
- Hall, T.A. BioEdit: A User-Friendly Biological Sequence Alignment Editor and Analysis Program for Windows 95/98/NT. Nucleic Acids Symp. Ser. 1999, 41, 95–98. [Google Scholar]
- L’Ollivier, C.; Cassagne, C.; Normand, A.C.; Bouchara, J.-P.; Contet-Audonneau, N.; Fourquet, P.; Coulibaly, O.; Piarroux, R.; Ranque, S. Identification Des Dermatophytes Par Spectrométrie de Masse MALDI-TOF. J. Mycol. Med. 2012, 22, 284–285. [Google Scholar] [CrossRef]
- Normand, A.C.; Becker, P.; Gabriel, F.; Cassagne, C.; Accoceberry, I.; Gari-Toussaint, M.; Hasseine, L.; Geyter, D.D.; Pierard, D.; Surmont, I.; et al. Validation of a New Web Application for Identification of Fungi by Use of Matrix-Assisted Laser Desorption Ionization–Time of Flight Mass Spectrometry. J. Clin. Microbiol. 2017, 55, 2661–2670. [Google Scholar] [CrossRef] [PubMed]
- Page, V. Le Hérisson, Emblême d’une Nature Réhabilitée; Ecole Nationale Vétérinaire de Nantes: Nantes, France, 2001. [Google Scholar]
- de Hoog, G.S.; Dukik, K.; Monod, M.; Packeu, A.; Stubbe, D.; Hendrickx, M.; Kupsch, C.; Stielow, J.B.; Freeke, J.; Göker, M.; et al. Toward a Novel Multilocus Phylogenetic Taxonomy for the Dermatophytes. Mycopathologia 2017, 182, 5–31. [Google Scholar] [CrossRef] [PubMed]
- Masaoodi, N.; Taha, B.; Al-Janabi, J. Occurrence, Morphological, and Molecular Characteristics of Trichophyton erinacei in Iraq. Drug Invent. Today 2020, 14, 889–896. [Google Scholar]
- Smith, J.M.B.; Marples, M.J. Trichophyton mentagrophytes var. erinacei. J. Med. Vet. Mycol. 1964, 3, 1–10. [Google Scholar] [CrossRef]
- Rosen, T.; Jablon, J. Infectious Threats from Exotic Pets: Dermatological Implications. Dermatol. Clin. 2003, 21, 229–236. [Google Scholar] [CrossRef]
- Robinson, I.; Routh, A. Veterinary Care of the Hedgehog. In Pract. 1999, 21, 128–137. [Google Scholar] [CrossRef]
- Takahashi, Y.; Haritani, K.; Sano, A.; Takizawa, K.; Fukushima, K.; Miyaji, M.; Nishimura, K. An Isolate of Arthroderma Benhamiae with Trichophyton mentagrophytes var. erinacei Anamorph Isolated from a Four-Toed Hedgehog (Atelerix albiventris) in Japan. Nippon Ishinkin Gakkai Zasshi 2002, 43, 249–255. [Google Scholar] [CrossRef][Green Version]
- Morris, P.; English, M.P. Transmission and Course of Trichophyton erinacei Infections in British Hedgehogs. Sabouraudia 1973, 11, 42–47. [Google Scholar] [CrossRef]
- Donnelly, T.M.; Rush, E.M.; Lackner, P.A. Ringworm in Small Exotic Pets. Semin. Avian Exot. Pet Med. 2000, 9, 82–93. [Google Scholar] [CrossRef]
- Morris, P.A. A Method for Determining Absolute Age in the Hedgehog. J. Zool. 1970, 161, 277–281. [Google Scholar] [CrossRef]
- English, M.P.; Morris, P. Trichophyton mentagrophytes var. erinacei in Hedgehog Nests. Sabouraudia 1969, 7, 118–121. [Google Scholar] [CrossRef] [PubMed]
- Majid, I.; Sheikh, G.; Kanth, F.; Hakak, R. Relapse after Oral Terbinafine Therapy in Dermatophytosis: A Clinical and Mycological Study. Indian. J. Dermatol. 2016, 61, 529–533. [Google Scholar] [PubMed]
- Hubka, V.; Peano, A.; Čmoková, A.; Guillot, J. Common and Emerging Dermatophytoses in Animals: Well-Known and New Threats. In Emerging and Epizootic Fungal Infections in Animals; Seyedmousavi, S., De Hoog, G.S., Guillot, J., Verweij, P.E., Eds.; Springer: Cham, Switzerland, 2018; pp. 31–79. ISBN 978-3-319-72091-3. [Google Scholar]
- Mantovani, A.; Morganti, L.; Battelli, G.; Mantovani, A.; Poglayen, G.; Tampieri, M.P.; Vecchi, G. The Role of Wild Animals in the Ecology of Dermatophytes and Related Fungi. Folia Parasitol 1982, 29, 279–284. [Google Scholar]
- Pier, A.C.; Moriello, K.A. Parasitic Relationship between Microsporum Canis and the Cat. Med. Mycol. 1998, 36 (Suppl. 1), 271–275. [Google Scholar] [PubMed]
- Viani, F.C.; Cazares Viani, P.R.; Gutierrez Rivera, I.N.; Gonçalves da Silva, E.; Rodrigues Paula, C.; Gambale, W. Extracellular Proteolytic Activity and Molecular Analysis of Microsporum canis Strains Isolated from Symptomatic and Asymptomatic Cats. Rev. Iberoam. Micol. 2007, 24, 19–23. [Google Scholar] [CrossRef]

| Sampling | T. erinacei | No Longer Followed (Released/Dead) | TOTAL | |
|---|---|---|---|---|
| Positive | Negative | |||
| First | 96 | 316 | - | 412 |
| Second | 44 | 90 | 278 | 412 |
| Third | 18 | 60 | 56 | 134 |
| Fourth | 9 | 27 | 42 | 78 |
| Fifth | 1 | 19 | 16 | 36 |
| Sixth | 1 | 4 | 15 | 20 |
| Seventh | 0 | 1 | 4 | 5 |
| Total | 169 | 517 | ||
Publisher’s Note: MDPI stays neutral with regard to jurisdictional claims in published maps and institutional affiliations. |
© 2021 by the authors. Licensee MDPI, Basel, Switzerland. This article is an open access article distributed under the terms and conditions of the Creative Commons Attribution (CC BY) license (http://creativecommons.org/licenses/by/4.0/).
Share and Cite
Le Barzic, C.; Cmokova, A.; Denaes, C.; Arné, P.; Hubka, V.; Guillot, J.; Risco-Castillo, V. Detection and Control of Dermatophytosis in Wild European Hedgehogs (Erinaceus europaeus) Admitted to a French Wildlife Rehabilitation Centre. J. Fungi 2021, 7, 74. https://doi.org/10.3390/jof7020074
Le Barzic C, Cmokova A, Denaes C, Arné P, Hubka V, Guillot J, Risco-Castillo V. Detection and Control of Dermatophytosis in Wild European Hedgehogs (Erinaceus europaeus) Admitted to a French Wildlife Rehabilitation Centre. Journal of Fungi. 2021; 7(2):74. https://doi.org/10.3390/jof7020074
Chicago/Turabian StyleLe Barzic, Cécile, Adela Cmokova, Chloé Denaes, Pascal Arné, Vit Hubka, Jacques Guillot, and Veronica Risco-Castillo. 2021. "Detection and Control of Dermatophytosis in Wild European Hedgehogs (Erinaceus europaeus) Admitted to a French Wildlife Rehabilitation Centre" Journal of Fungi 7, no. 2: 74. https://doi.org/10.3390/jof7020074
APA StyleLe Barzic, C., Cmokova, A., Denaes, C., Arné, P., Hubka, V., Guillot, J., & Risco-Castillo, V. (2021). Detection and Control of Dermatophytosis in Wild European Hedgehogs (Erinaceus europaeus) Admitted to a French Wildlife Rehabilitation Centre. Journal of Fungi, 7(2), 74. https://doi.org/10.3390/jof7020074

